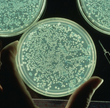

The Immunology & Microbiology Graduate Program links scientists from across the College to foster innovative, collaborative research in microbiology and immunology. Faculty members have the freedom to select the programs that align with their research. Rather than be bound by the department or center into which they were hired, faculty opt into participation in graduate programs. This ensures that you will interact with faculty who bring diverse backgrounds and perspectives across the full depth and breadth of immunology and microbiology.
Our faculty work within the following research areas. Explore each topic to find faculty whose interests match your own.
Antibiotics, Antivirals and Drug Resistance
Autoimmune and Inflammatory Diseases
Host-Microbe Interactions and Pathogenesis
Immune System Development, Metabolism and Function
Immunotherapy, Gene Therapy and Vaccine Development
Mechanisms of Viral Replication
Microbial Macromolecular Structure and Function
Microbiome in Health and Disease
Molecular and Viral Carcinogenesis and Cancer Immunology
"The faculty really cares about me growing and having everything I need as a student to succeed in my future career. This is true for technical skills, knowledge, and the soft skills that are in such high demand in any science field. They ask, "What do you want out of your education," and then respond with initiatives that provide what we need. I have no doubt that I will go into my career with everything that I need to succeed. I feel like the most spoiled graduate student having all of these collaborating researchers and institutions at my feet." - Kristyn Hoffman, Ph.D. Student
Research Resources
As a student in the Immunology & Microbiology Graduate Program, you will have access to the all the resources of Baylor College of Medicine as well as those of leading research institutions in the world's largest medical complex.

Center for Translational Research on Inflammatory Diseases
The goals of CTRID are to increase basic and clinical research funding at Michael E. DeBakey Veteran's Affairs Medical Center, enhance interaction among investigators at VA, and foster mentoring of early career investigators.

Advanced Technology Cores
Advanced technology core laboratories provide state-of-the-art instrumentation and technologies as well as consultation on experimental design, data analysis and training. Through the cores, you will not only gain access to tools and techniques that support your research, you will also receive training and mentorship in how to leverage these tools to develop innovative approaches to scientific challenges.
Alkek Center for Metagenomics and Microbiome Research
The CMMR serves as an international hub for the development and implementation of advanced technologies for the understanding of how the microbiome impacts health and disease, and for the translation of this knowledge into microbiome based therapeutics and diagnostics.

Biology of Inflammation Center
The Biology of Inflammation Center is dedicated to the support of translational immunology research at Baylor through a faculty that includes investigators from diverse fields with broad research interests within the field of immunology.

Center for Cell and Gene Therapy
The Center for Cell and Gene Therapy at Baylor College of Medicine, Texas Children's Hospital, and Houston Methodist Hospital provides an infrastructure to rapidly translate novel cell and gene therapy protocols from the laboratory to the clinic. The comprehensive approach of the center brings a wide variety of scientists and clinicians together to develop strategies for the treatment of cancer, HIV and cardiovascular disease.

Designated a Comprehensive Cancer Center by the National Cancer Institute, the Dan L Duncan Comprehensive Cancer Center provides exceptional patient care, outstanding education for students, and innovative research into the causes, prevention and treatment of cancer, and community outreach and education, especially to the underserved.

National School of Tropical Medicine
Our National School of Tropical Medicine is one of the first of its kind in North America devoted to the neglected diseases that disproportionately afflict "the bottom billion," the world's poorest people who live below the World Bank poverty level.

Texas Children's Hospital Center for Vaccine Development
Texas Children's Hospital Center for Vaccine Development is dedicated to the discovery and development of vaccines against neglected tropical diseases and other emerging infectious diseases.

Texas Medical Center Digestive Diseases Center
The Texas Medical Center Digestive Diseases Center (TMC DDC) facilitates cutting-edge digestive diseases research, promotes translational collaborative research between basic and clinical areas, develops new projects, nurtures new investigators, and provides GI educational activities.
Texas Medical Center
The concentration of research in every aspect of biomedical sciences in the Texas Medical Center and in Houston is among the highest to be found anywhere. Through an extensive network of affiliations, you will have access to extensive interactions and collaborations with researchers from the full spectrum of physical and social sciences.
A group of researchers led by Dr. Christine Beeton at Baylor College of Medicine has found that one of the hundreds of components in scorpion venom can reduce the severity of the disease in animal models, without inducing side effects associated with similar treatments.
Dr. Peter Hotez, Dean of the National School of Tropical Medicine at Baylor College of Medicine, discusses his book, Blue Marble Health.
 Credit
Credit
Andrew Sikora, Ph.D., MD, co-director of the Head and Neck Cancer Program at Baylor College of Medicine, describes how clinical trials are demonstrating the amazing power of immunotherapy to train the patient’s own immune system to destroy cancer cells.
Dr. Joseph Petrosino, director of the Alkek Center for Metagenomics and Microbiome Studies, discusses BCM's role in the Human Microbiome Project.
Assistant professor of pediatrics - infectious disease Dr. Katherine King and postdoctoral fellow Dr. Katie Matatall discuss their work revealing that long-lasting infections trigger the loss of stem cells.
 Credit
Credit
Highlights of research on soft ticks and the bacteria they transmit, featuring Dr. Job Lopez.









